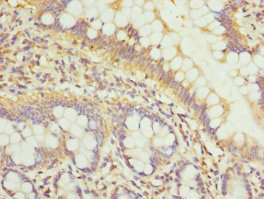

GALNT3 Antibody
-
中文名稱:GALNT3兔多克隆抗體
-
貨號:CSB-PA613501ESR1HU
-
規格:¥440
-
圖片:
-
其他:
產品詳情
-
產品名稱:Rabbit anti-Homo sapiens (Human) GALNT3 Polyclonal antibody
-
Uniprot No.:
-
基因名:GALNT3
-
別名:DKFZp686C10199 antibody; EC 2.4.1.41 antibody; GalNAc T3 antibody; GalNAc transferase 3 antibody; GalNAc-T3 antibody; GalNAcT3 antibody; GALNT3 antibody; GALT3_HUMAN antibody; HFTC antibody; HHS antibody; MGC61909 antibody; OTTHUMP00000204915 antibody; OTTHUMP00000204919 antibody; Polypeptide GalNAc transferase 3 antibody; Polypeptide GalNAc transferase T3 antibody; Polypeptide N acetylgalactosaminyltransferase 3 antibody; Polypeptide N-acetylgalactosaminyltransferase 3 antibody; pp-GaNTase 3 antibody; ppGaNTase 3 antibody; Protein UDP acetylgalactosaminyltransferase 3 antibody; Protein-UDP acetylgalactosaminyltransferase 3 antibody; RP23-306G16.2 antibody; UDP GalNAc:polypeptide N acetylgalactosaminyltransferase 3 antibody; UDP N acetyl alpha D galactosamine:polypeptide N acetylgalactosaminyltransferase 3 (GalNAc T3) antibody; UDP-GalNAc:polypeptide N-acetylgalactosaminyltransferase 3 antibody; UDP-N-acetyl-alpha-D-galactosamine:polypeptide N-acetylgalactosaminyltransferase 3 antibody
-
宿主:Rabbit
-
反應種屬:Human
-
免疫原:Recombinant Human Polypeptide N-acetylgalactosaminyltransferase 3 protein (1-140AA)
-
免疫原種屬:Homo sapiens (Human)
-
標記方式:Non-conjugated
-
克隆類型:Polyclonal
-
抗體亞型:IgG
-
純化方式:Antigen Affinity Purified
-
濃度:It differs from different batches. Please contact us to confirm it.
-
保存緩沖液:PBS with 0.02% sodium azide, 50% glycerol, pH7.3.
-
產品提供形式:Liquid
-
應用范圍:ELISA, IHC
-
推薦稀釋比:
Application Recommended Dilution IHC 1:20-1:200 -
Protocols:
-
儲存條件:Upon receipt, store at -20°C or -80°C. Avoid repeated freeze.
-
貨期:Basically, we can dispatch the products out in 1-3 working days after receiving your orders. Delivery time maybe differs from different purchasing way or location, please kindly consult your local distributors for specific delivery time.
-
用途:For Research Use Only. Not for use in diagnostic or therapeutic procedures.
相關產品
靶點詳情
-
功能:Catalyzes the initial reaction in O-linked oligosaccharide biosynthesis, the transfer of an N-acetyl-D-galactosamine residue to a serine or threonine residue on the protein receptor. Has activity toward HIV envelope glycoprotein gp120, EA2, Muc2 and Muc5. Probably glycosylates fibronectin in vivo. Glycosylates FGF23. Plays a central role in phosphate homeostasis.
-
基因功能參考文獻:
- GalNAc-T3 was highly expressed by motile spermatozoa and the expression correlated positively with the classical semen parameters. PMID: 30262754
- Study shows that ZEB2 negatively regulates a GalNAc-transferase (GALNT3) that is involved in O-glycosylation adds another layer of complexity to the role of ZEB2 in cancer progression and metastasis. PMID: 29516288
- Giantin-knockout zebrafish exhibit hyperostosis and ectopic calcium deposits, recapitulating phenotypes of hyperphosphatemic familial tumoral calcinosis, a disease caused by mutations in GALNT3. These data reveal a new feature of Golgi homeostasis: the ability to regulate glycosyltransferase expression to generate a functional proteoglycome. PMID: 29093022
- study supports an essential role of GALNT3 in Epithelial ovarian cancer dissemination, including its implication in modulating post-translational modifications and EOC metabolism PMID: 27095597
- The acetylated residues on ppGalNAc-T3 function as control points for enzyme activity, and high level of GlcNAc glycosides promote a synergistic regulatory mechanism, leading to a metabolically disordered state. PMID: 28672761
- This study identified GALNT3 as a novel gene that rendered patients susceptible to coronary artery disease (CAD), and the A allele of a disease-associated variant rs4621175 linked reduced CAD risk through decreased GALNT3 expression. PMID: 28453302
- Study indicates that loss of GALNT3 occurs in poorly differentiated PDAC, which is associated with the increased aggressiveness and altered glycosylation of ErbB family proteins. PMID: 27187683
- GalNAc-T3 might play a role in the pathogenesis of early stage oral squamous cell carcinoma recurrence PMID: 26296622
- MGAT5 expression is a potential independent adverse prognostic biomarker for recurrence and survival of patients with ccRCC after nephrectomy. PMID: 25630622
- Two microRNAs (miRNAs), miR-17-3p and miR-221, which target GalNAc transferase 3 (GALNT3) mRNA, are rapidly downregulated in human alveolar basal epithelial cells during the early stage of influenza A virus infection. PMID: 26637460
- hyperphosphatemic familial tumoral calcinosis and hyperphosphatemic hyperostosis syndrome caused by a novel GALNT3 mutation PMID: 25249269
- Polymorphisms of rs1863196, rs6710518, rs4667492, rs1349321 and rs6721582 (GALNT3) are associated with bone mineral density.GALNT3 may play a role in genetic susceptibility to postmenopausal osteoporosis in Chinese womeh. PMID: 24045674
- Data are indicative for a strong oncogenic potential of the GALNT3 gene in advanced EOC and identify this transferase as a novel EOC biomarker. PMID: 24504219
- Our data suggest that GalNAc-T3 expression may be a useful indicator of tumor differentiation in thyroid carcinomas. PMID: 23659732
- we integrated different computational tools to perform the in silico analysis of clinically significant mutations (nsSNPs/single amino acid change) at both functional and structural levels, found in human GALNT3, GALNT8, GALNT12, and GALNT13 genes. PMID: 24038392
- GalNac transferase transgenic knock-out mice neurons have significantly increased rates of axon degeneration. PMID: 24431446
- N-acetylgalactosaminyltransferases-3 expression independently predicts high-grade tumour and poor prognosis in patients with renal cell carcinomas. PMID: 23799843
- a novel homozygous missense mutation affecting highly conserved amino acids in GALNT3 in patients with hyperphosphatemic familial tumoral calcinosis PMID: 21347749
- GalNAc-T3 is likely involved in pancreatic carcinogenesis PMID: 21625220
- GALNT3 is associted with bone mineral density variation. PMID: 21533022
- Mutational analysis of FGF23 and GALNT3 in patients with hyperphosphatemia and clinical manifestations including tumoral calcinosis revealed novel homozygous mutations in GALNT3. PMID: 20358599
- The genetic predisposition to calcinosis and hyperostosis-hyperphosphataemia syndrome due to missense mutations in GALNT3 protein. PMID: 19830424
- N-acetylgalactosaminyl transferase-3 is a potential new marker for non-small cell lung cancers. PMID: 12232759
- the expression of GalNAc-T3 is associated with the differentiation and aggressiveness of ductal adenocarcinoma of the pancreas PMID: 14555840
- Low expression of GalNAc-T3 was associated with poorly differentiated tumor, poor pathologic stage, lymph node metastasis, and tumour recurrence in lung adenocarcinoma PMID: 14735190
- In gallbladder cancer, the presence of diffuse-type localization of GalNAc-T3 in the subserosal layer is correlated with aggressiveness of the diseases. PMID: 15041730
- mapped the gene underlying familial tumoral calcinosis to 2q24-q31.This region includes the gene GALNT3. Sequence analysis of GALNT3 identified biallelic deleterious mutations, suggesting defective post-translational modification. PMID: 15133511
- GalNAc-T3 may play a positive role in the process of carcinogenesis and progression in esophageal squamous cell carcinoma (SCC) and functional inhibition of GalNAc-T3 may be effective for the prevention and treatment of esophageal SCC. PMID: 15860931
- GalNAc-T3 selectively directs O-glycosylation in a subtilisin-like proprotein convertase recognition sequence motif, which blocks processing of FGF23 PMID: 16638743
- Calcinosis presenting with eyelid calcifications due to novel missense mutations in GALNT3. PMID: 16940445
- mutation analyses of GALNT3 in a subject with hyperphosphatemic familial tumoral calcinosis and in his relatives; first report describing the simultaneous presence of two different stop codons in the coding sequence of the GALNT3 gene PMID: 17351710
- Extra hepatic bile duct carcinomas alter their GalNAc-T3 expression during tumor growth, and the difference in the expression pattern may be associated with lymph node metastasis. PMID: 17361208
- we have detected novel GALNT3 mutations that result in familial TC, and show that disturbed serum FGF23 concentrations are present in our TC cases PMID: 17853462
- study identified a Beninese family in which two brothers present Familial Tumoral Calcinosis caused by a homozygous A>T transversion at the acceptor splice site in intron 1 of the GALNT3 gene PMID: 18618993
- decreased GALNT3 expression in skin fibroblasts leads to increased expression of FGF7 and of matrix metalloproteinases, which have been previously implicated in the pathogenesis of ectopic calcification PMID: 18976705
- Mutations in the UDP-N-acetyl-alpha-D-galactosamine: polypeptide N-acetylgalactosaminyltransferase-3 (GALNT3) and fibroblast growth factor-23 (FGF23) genes have been described in tumoral calcinosis. PMID: 19411468
顯示更多
收起更多
-
相關疾病:Tumoral calcinosis, hyperphosphatemic, familial (HFTC)
-
亞細胞定位:Golgi apparatus, Golgi stack membrane; Single-pass type II membrane protein. Note=Resides preferentially in the trans and medial parts of the Golgi stack.
-
蛋白家族:Glycosyltransferase 2 family, GalNAc-T subfamily
-
組織特異性:Expressed in organs that contain secretory epithelial glands. Highly expressed in pancreas, skin, kidney and testis. Weakly expressed in prostate, ovary, intestine and colon. Also expressed in placenta and lung and fetal lung and fetal kidney.
-
數據庫鏈接:
Most popular with customers
-
-
YWHAB Recombinant Monoclonal Antibody
Applications: ELISA, WB, IHC, IF, FC
Species Reactivity: Human, Mouse, Rat
-
Phospho-YAP1 (S127) Recombinant Monoclonal Antibody
Applications: ELISA, WB, IHC
Species Reactivity: Human
-
-
-
-
-